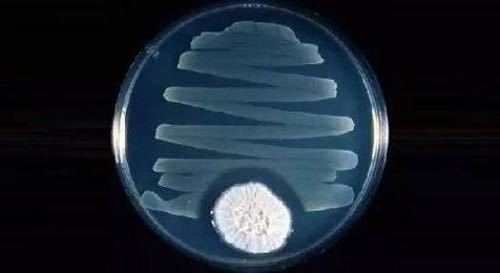

你好,欢迎来到《医学通识50讲》,我是薄世宁。
先请你看下面这幅漫画。
漫画里,两个远古人坐在山洞里讨论人生。他俩说:
“有个事儿好像不大对劲。”
“有啥不对劲儿呢?”
“咱们的空气是干净的,咱们喝的水是纯净水,咱们锻炼也足够,咱们的食物都是有机和野生的。为啥却没人能活过30岁呢?”

你想过这个问题没有呢?
为什么远古人活得这么“绿色”,却活不过30岁?
咱们和雾霾斗,和压力斗,和农药斗,但是咱们的平均预期寿命已经接近80岁了。
让我说,今天人类的寿命大大延长,其中一项重要的原因,就是巧妙地利用了物种竞争。
这节课请你记住这四个字——物种竞争。
利用物种竞争治疗感染
从古至今,咱们一直笼罩在致病微生物的威胁之下。
在古代,甚至不经意划破皮都有可能要了命。致病微生物想侵入人体获取营养,这就是物种之间的竞争。
更严重的是烈性传染病,比如鼠疫。
鼠疫也叫黑死病。引起鼠疫的就是一种毒力和传染性都很强的细菌——鼠疫杆菌。
1347年欧洲爆发鼠疫,夺走了2500万人的生命,占到当时欧洲总人口的1/3。在意大利的佛罗伦萨,80%的人在这场鼠疫中丧命。
有作家曾经写到:
很多人上午刚把亲人的尸体拉去焚烧,到了晚上,自己的尸体又要被别人拖走烧掉,就这么惨。
这次鼠疫过后,欧洲人口用了大约150年才恢复。
鼠疫和很多细菌感染性疾病,比如肺结核、淋病、细菌性肺炎等,这些病告诉咱们:很多毒力很强的细菌,单纯依靠人体免疫,对抗不了。
这种状况一直持续到一个药的发现——青霉素。
关于青霉素,你肯定了解不少。
比如,1928年英国的弗莱明博士(Alexander Fleming)在实验室发霉的培养基中,偶然发现了青霉素。
再比如,弗洛里(Howard Walter Florey)和钱恩(Ernst Chain)完成了青霉素的提纯,并促成了青霉素的量产。
青霉素的发明,让这三位科学家分享1945年的诺贝尔生理学或医学奖。
还有,盟军诺曼底登陆,不仅准备了无数的枪支弹药,还准备了10万支青霉素。二战中青霉素挽救了无数伤员。
那么,一支小小的青霉素,为什么可以救这么多命呢?
研究表明,以青霉素为代表的β-内酰胺类抗生素,作用机制就是干扰了细菌细胞壁的合成。
我们熟悉的头孢,就是β-内酰胺类抗生素。
要知道,咱们人体的细胞是没有细胞壁的,所以青霉素杀细菌效果好,同时对人体细胞伤害很小。这是药理学家的解释。
我再带你再深想一层。
再回到90多年前,弗莱明博士偶然发现青霉素的现场,这里面有个细节。弗莱明发现,在长了霉菌的培养基周围,没有细菌生长。
为什么真菌周围不长细菌呢?一定是真菌分泌的什么东西,抑制或者杀死了细菌。
为什么真菌要和细菌过不去呢?
对,这又是另一种物种竞争关系。
咱们人体内,不仅有细菌,还有真菌。在数以百万年的演化过程中,人、细菌、真菌形成了一种既相互依存,又相互竞争的关系。
平时大家和谐共处,这是共生,但是在抵抗力低,或者人体某个部位有了破损,或者遇到毒力强的致病微生物侵入人体的时候,三者就成了你死我活的竞争关系。
既然在严重感染的状态下,人体的免疫力很难清除细菌。那么,用真菌分泌的物质,也就是青霉素,就可以杀死细菌。
人体是真菌生存的环境,所以,这种真菌分泌的物质,一定不能对人有太大伤害,否则一起玩完谁也得不到好处。因此,青霉素对细菌杀伤效果好,但是对人的伤害却很小。
青霉素就是第一个抗生素。
“抗生”的意思,就是一种微生物对另外一种微生物的生长繁殖有抑制或者杀灭作用。一种微生物分泌的,可以抑制或者杀死对方的物质,就是抗生素。
所以,用青霉素治疗细菌感染,就是用真菌分泌的物质去杀死细菌,这是巧妙地利用了物种之间天然的竞争关系。
这就是青霉素的工作原理,是理解的物种竞争关系的第一个层面:利用物种竞争治疗感染。
过度使用抗生素带来的问题
青霉素的出现带来了一个抗生素时代。
人类又研发或者合成了其他种类的抗生素,作用原理也不再只是干扰细胞壁的合成。比如,有的是影响细菌蛋白的合成,有的是阻碍细菌DNA的合成。
抗生素的出现,给人类对抗细菌提供了一把利器。
以前很多治不了的病,今天能治了。比如细菌性肺炎、细菌性尿路感染等等。
那么,人类有了抗生素,是不是就“无敌”了呢?
我们今天担心的所谓抗生素的耐药,以及二重感染等问题,从抗生素发现的那一天,就埋下了种子。
在细菌感染的时候,用抗生素是为了治病,为了救命。
不容忽视的是,抗生素是把物种天然的竞争关系,人为拿出来利用。
长期使用的话,对抗生素敏感的细菌就杀光了,这时候,另一些不敏感的细菌就会过度繁殖,细菌也会演化出适应抗生素环境的生存方式。这就是耐药。
这部分细菌会把耐药的遗传物质,通过接触传递给周围的细菌,也通过繁殖传递给它的后代。
人类研发一种新型抗生素,要用数年甚至十几年。但是,细菌只需几个小时就能完成一次进化和迭代。
所以,再强、再新的抗生素,也不可能杀光所有的细菌。杀不掉的细菌终将耐药。这就是细菌对抗生素的耐药现象。
除了耐药问题,大量应用抗生素,还会打破肠道内细菌的内共生关系。关于内共生,在前面的课程《第10讲 内共生:认知疾病的新角度》里讲过,这里就不多说了。
打破内共生就会引起菌群紊乱。我举个极端的例子。
在医院,因为严重感染性疾病,需要大量使用抗生素的病人,会出现顽固的腹泻。就是因为抗生素打破了原本的菌群平衡,导致菌群紊乱。
这种腹泻很难治,那怎么办呢?
既然是抗生素破坏了物种的平衡,那最好的办法就是恢复平衡。
有一种办法,就是把健康人的粪便提取液,也就是健康人的肠道细菌,打到病人的肠道里,很多病人的腹泻就能止住。
大量广谱抗生素应用,还会带来真菌感染。
为什么呢?
我们利用物种竞争,利用真菌分泌的物质杀死了细菌,谁最高兴呢?
当然是真菌了。
真菌过度生长,也会带来真菌感染。大量使用广谱抗生素的病人就会出现深部真菌感染,这类感染就更难治了。
我再举个日常生活中的例子。
很多女生受到广告误导,动不动就用含有杀菌剂的洗液冲洗阴道。阴道本身就是一个充满细菌的环境,用洗液就破坏了阴道本身的菌群平衡,反而会引起真菌感染。
很多阴道炎,尤其是真菌性阴道炎都与阴道的微生态失调有关。
这是关于物种竞争的第二个层面:过度利用抗生素,会带来细菌耐药、菌群紊乱,继发真菌感染。
科学使用抗生素的三条建议
到底该不该用抗生素呢?有了感染,“死扛着”是不是就更安全呢?
这种态度肯定不对。作为医生,我给你三条使用抗生素的建议:
第一,在医生的指导下规范应用,抗生素是好药,不会带来多大的副作用。
所以,在严重感染的时候一定要用抗生素,不要排斥。而且要早用,按疗程用。
第二,任何感染都不能单纯地“杀”,除了应用抗生素之外,应该鼓励人体的自我防御。
我在前面课程里讲过,比如发烧、咳嗽、腹泻,这些都是人体清除细菌的自我防御机制,如果不是过度反应,尽量不要压制。
比如,把痰咳出来,就是身体的一种自我防御。很多病情严重的病人没办法自主咳痰,这样就很危险。
所以在医院,对于严重的肺炎病人,医生和护士时刻都在鼓励病人咳痰。咳不出来的,医生还会用气管镜吸痰,这些都是在激励人体本来的自我防御机制。
危重病人能否战胜疾病的一个重要指标,就是看他是否恢复了有效的咳痰能力。
第三,少备抗生素。
家里的小药箱,可以备退烧药、感冒药、平时吃的慢性病用药,但是我认为不要准备太多的抗生素。
别自己滥用抗生素。关于抗生素用不用,怎么用,还是应该咨询医生,根据处方购买和治疗。
下节预告
任何治疗的前提,都要保证人活着。下一讲,我们讲讲热修复的新起点——呼吸机。